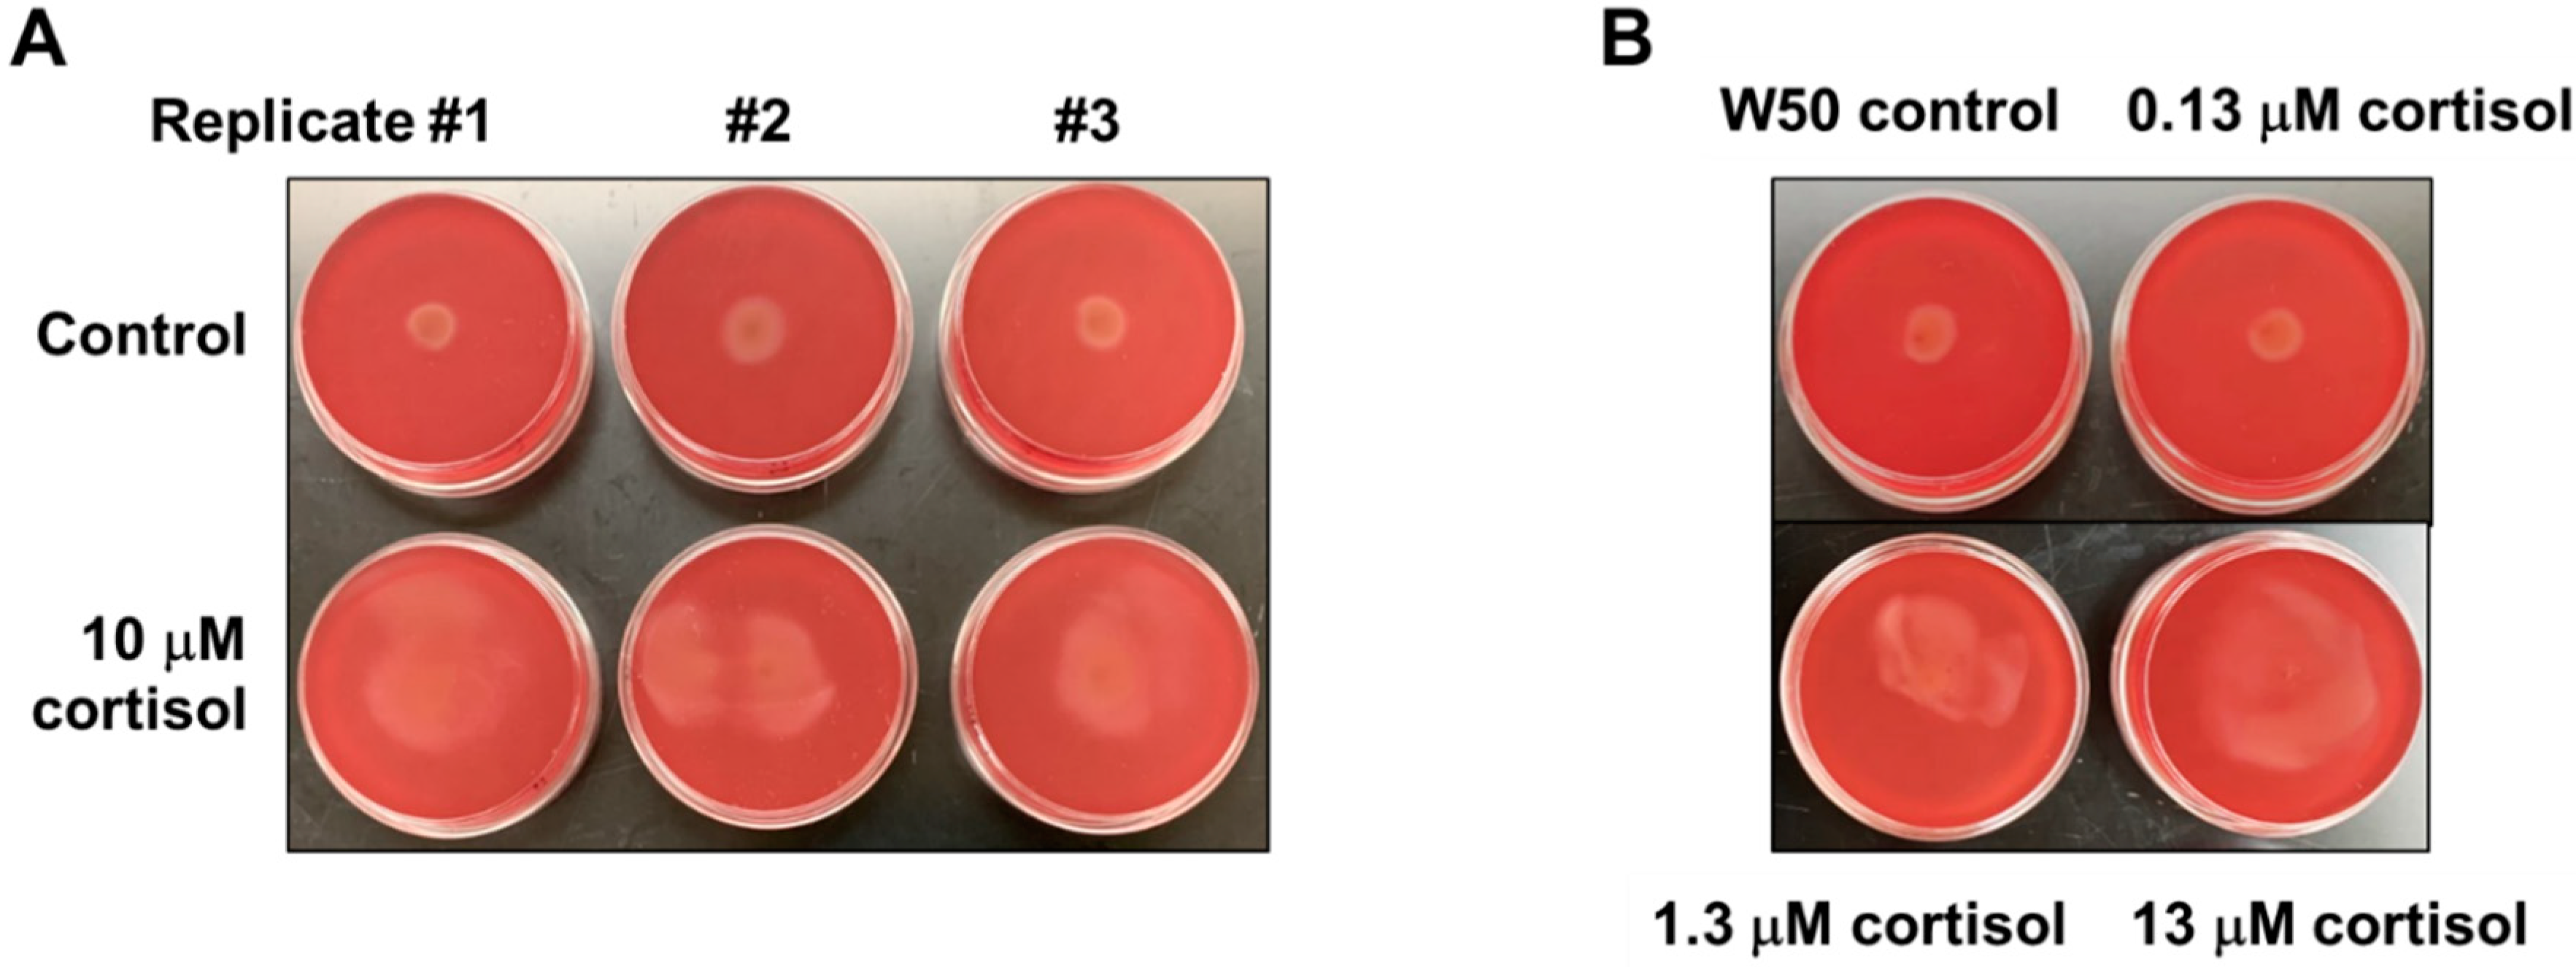
Pathogens 11 00982 g001

Cortisol Promotes Surface Translocation of Porphyromonas gingivalis
Abstract
:1. Introduction
2. Materials and Methods
2.1. Bacterial Strains and Culture Conditions
2.2. Stabbing to the Subsurface of Soft Agar Plates (Macroscopic Migration Assay)
2.3. Construction of Mutants and in Trans Complementation
2.4. Microscopy Imaging
2.5. RNA Extraction, and Quantitative PCR (qPCR) Analysis
3. Results
3.1. Cortisol Promotes Surface Translocation of P. gingivalis in a Concentration-Dependent Manner
3.2. Cortisol Promotes P. gingivalis Migration in Rich Medium with the Addition of Lactate or Pyruvate
3.3. Genetic Responses of P. gingivalis Surface Translocation-Associated Genes Are Substantially Altered in the Presence of Cortisol
3.4. The mfa5 Deletion Mutant Showed Less Surface Translocation Compared with the Parent Strain in the Presence of Cortisol
4. Discussion
5. Conclusions
Supplementary Materials
Author Contributions
Funding
Institutional Review Board Statement
Informed Consent Statement
Data Availability Statement
Acknowledgments
Conflicts of Interest
References
- Hajishengallis, G.; Lamont, R.J. Dancing with the Stars: How Choreographed Bacterial Interactions Dictate Nososymbiocity and Give Rise to Keystone Pathogens, Accessory Pathogens, and Pathobionts. Trends Microbiol. 2016, 24, 477–489. [Google Scholar] [CrossRef] [PubMed]
- Gur, T.L.; Worly, B.L.; Bailey, M.T. Stress and the commensal microbiota: Importance in parturition and infant neurodevelopment. Front. Psychiatry 2015, 6, 5. [Google Scholar] [CrossRef] [PubMed]
- Jentsch, H.F.; Marz, D.; Kruger, M. The effects of stress hormones on growth of selected periodontitis related bacteria. Anaerobe 2013, 24, 49–54. [Google Scholar] [CrossRef]
- Roberts, A.; Matthews, J.B.; Socransky, S.S.; Freestone, P.P.; Williams, P.H.; Chapple, I.L. Stress and the periodontal diseases: Effects of catecholamines on the growth of periodontal bacteria in vitro. Oral Microbiol. Immunol. 2002, 17, 296–303. [Google Scholar] [CrossRef]
- Duran-Pinedo, A.E.; Solbiati, J.; Frias-Lopez, J. The effect of the stress hormone cortisol on the metatranscriptome of the oral microbiome. NPJ Biofilms Microbiomes 2018, 4, 25. [Google Scholar] [CrossRef]
- Rai, B.; Kaur, J.; Anand, S.C.; Jacobs, R. Salivary stress markers, stress, and periodontitis: A pilot study. J. Periodontol. 2011, 82, 287–292. [Google Scholar] [CrossRef]
- Ishisaka, A.; Ansai, T.; Soh, I.; Inenaga, K.; Awano, S.; Yoshida, A.; Hamasaki, T.; Sonoki, K.; Takata, Y.; Nishihara, T.; et al. Association of cortisol and dehydroepiandrosterone sulphate levels in serum with periodontal status in older Japanese adults. J. Clin. Periodontol. 2008, 35, 853–861. [Google Scholar] [CrossRef]
- Genco, R.J.; Ho, A.W.; Kopman, J.; Grossi, S.G.; Dunford, R.G.; Tedesco, L.A. Models to evaluate the role of stress in periodontal disease. Ann. Periodontol. 1998, 3, 288–302. [Google Scholar] [CrossRef] [PubMed]
- Socransky, S.S.; Haffajee, A.D.; Cugini, M.A.; Smith, C.; Kent, R.L., Jr. Microbial complexes in subgingival plaque. J. Clin. Periodontol. 1998, 25, 134–144. [Google Scholar] [CrossRef]
- Socransky, S.S.; Haffajee, A.D. Periodontal microbial ecology. Periodontology 2000 2005, 38, 135–187. [Google Scholar] [CrossRef]
- Haffajee, A.D.; Socransky, S.S. Microbial etiological agents of destructive periodontal diseases. Periodontology 2000 1994, 5, 78–111. [Google Scholar] [CrossRef] [PubMed]
- Singhrao, S.K.; Olsen, I. Assessing the role of Porphyromonas gingivalis in periodontitis to determine a causative relationship with Alzheimer’s disease. J. Oral Microbiol. 2019, 11, 1563405. [Google Scholar] [CrossRef] [PubMed]
- Scher, J.U.; Abramson, S.B. Periodontal disease, Porphyromonas gingivalis, and rheumatoid arthritis: What triggers autoimmunity and clinical disease? Arthritis Res. Ther. 2013, 15, 122. [Google Scholar] [CrossRef] [PubMed]
- Olsen, I.; Yilmaz, O. Possible role of Porphyromonas gingivalis in orodigestive cancers. J. Oral Microbiol. 2019, 11, 1563410. [Google Scholar] [CrossRef] [PubMed]
- Koziel, J.; Mydel, P.; Potempa, J. The Link Between Periodontal Disease and Rheumatoid Arthritis: An Updated Review. Curr. Rheumatol. Rep. 2014, 16, 408. [Google Scholar] [CrossRef]
- Carter, C.J.; France, J.; Crean, S.; Singhrao, S.K. The Porphyromonas gingivalis/Host Interactome Shows Enrichment in GWASdb Genes Related to Alzheimer’s Disease, Diabetes and Cardiovascular Diseases. Front. Aging Neurosci. 2017, 9, 408. [Google Scholar] [CrossRef]
- Bui, F.Q.; Almeida-da-Silva, C.L.C.; Huynh, B.; Trinh, A.; Liu, J.; Woodward, J.; Asadi, H.; Ojcius, D.M. Association between periodontal pathogens and systemic disease. Biomed. J. 2019, 42, 27–35. [Google Scholar] [CrossRef]
- Dominy, S.S.; Lynch, C.; Ermini, F.; Benedyk, M.; Marczyk, A.; Konradi, A.; Nguyen, M.; Haditsch, U.; Raha, D.; Griffin, C.; et al. Porphyromonas gingivalis in Alzheimer’s disease brains: Evidence for disease causation and treatment with small-molecule inhibitors. Sci. Adv. 2019, 5, eaau3333. [Google Scholar] [CrossRef]
- Nakayama, K. Porphyromonas gingivalis and related bacteria: From colonial pigmentation to the type IX secretion system and gliding motility. J. Periodontal. Res. 2015, 50, 1–8. [Google Scholar] [CrossRef]
- Declercq, A.M.; Cai, W.; Naranjo, E.; Thongda, W.; Eeckhaut, V.; Bauwens, E.; Arias, C.; De La Fuente, L.; Beck, B.H.; Lange, M.D.; et al. Evidence that the stress hormone cortisol regulates biofilm formation differently among Flavobacterium columnare isolates. Vet. Res. 2019, 50, 24. [Google Scholar] [CrossRef] [Green Version]
- Sato, K.; Naito, M.; Yukitake, H.; Hirakawa, H.; Shoji, M.; McBride, M.J.; Rhodes, R.G.; Nakayama, K. A protein secretion system linked to bacteroidete gliding motility and pathogenesis. Proc. Natl. Acad. Sci. USA 2010, 107, 276–281. [Google Scholar] [CrossRef]
- Moradali, M.F.; Ghods, S.; Angelini, T.E.; Davey, M.E. Amino acids as wetting agents: Surface translocation by Porphyromonas gingivalis. ISME J. 2019, 13, 1560–1574. [Google Scholar] [CrossRef]
- Grenier, D.; Gauthier, P.; Plamondon, P.; Nakayama, K.; Mayrand, D. Studies on the aminopeptidase activities of Porphyromonas gingivalis. Oral Microbiol. Immunol. 2001, 16, 212–217. [Google Scholar] [CrossRef] [PubMed]
- Lamont, R.J.; Jenkinson, H.F. Life below the gum line: Pathogenic mechanisms of Porphyromonas gingivalis. Microbiol. Mol. Biol. Rev. 1998, 62, 1244–1263. [Google Scholar] [CrossRef] [PubMed]
- Oda, H.; Saiki, K.; Tonosaki, M.; Yajima, A.; Konishi, K. Participation of the secreted dipeptidyl and tripeptidyl aminopeptidases in asaccharolytic growth of Porphyromonas gingivalis. J. Periodontal Res. 2009, 44, 362–367. [Google Scholar] [CrossRef] [PubMed]
- Madej, M.; White, J.B.R.; Nowakowska, Z.; Rawson, S.; Scavenius, C.; Enghild, J.J.; Bereta, G.P.; Pothula, K.; Kleinekathoefer, U.; Basle, A.; et al. Structural and functional insights into oligopeptide acquisition by the RagAB transporter from Porphyromonas gingivalis. Nat. Microbiol. 2020, 5, 1016–1025. [Google Scholar] [CrossRef]
- Moradali, M.F.; Davey, M.E. Metabolic plasticity enables lifestyle transitions of Porphyromonas gingivalis. NPJ Biofilms Microbiomes 2021, 7, 46. [Google Scholar] [CrossRef]
- Enersen, M.; Nakano, K.; Amano, A. Porphyromonas gingivalis fimbriae. J. Oral Microbiol. 2013, 5, 20265. [Google Scholar] [CrossRef]
- Hasegawa, Y.; Iijima, Y.; Persson, K.; Nagano, K.; Yoshida, Y.; Lamont, R.J.; Kikuchi, T.; Mitani, A.; Yoshimura, F. Role of Mfa5 in Expression of Mfa1 Fimbriae in Porphyromonas gingivalis. J. Dent. Res. 2016, 95, 1291–1297. [Google Scholar] [CrossRef]
- Heidler, T.V.; Ernits, K.; Ziolkowska, A.; Claesson, R.; Persson, K. Porphyromonas gingivalis fimbrial protein Mfa5 contains a von Willebrand factor domain and an intramolecular isopeptide. Commun. Biol. 2021, 4, 106. [Google Scholar] [CrossRef]
- Whittaker, C.A.; Hynes, R.O. Distribution and evolution of von Willebrand/integrin A domains: Widely dispersed domains with roles in cell adhesion and elsewhere. Mol. Biol. Cell 2002, 13, 3369–3387. [Google Scholar] [CrossRef] [PubMed]
- Konto-Ghiorghi, Y.; Mairey, E.; Mallet, A.; Dumenil, G.; Caliot, E.; Trieu-Cuot, P.; Dramsi, S. Dual role for pilus in adherence to epithelial cells and biofilm formation in Streptococcus agalactiae. PLoS Pathog. 2009, 5, e1000422. [Google Scholar] [CrossRef] [PubMed]
- Nielsen, H.V.; Guiton, P.S.; Kline, K.A.; Port, G.C.; Pinkner, J.S.; Neiers, F.; Normark, S.; Henriques-Normark, B.; Caparon, M.G.; Hultgren, S.J. The metal ion-dependent adhesion site motif of the Enterococcus faecalis EbpA pilin mediates pilus function in catheter-associated urinary tract infection. mBio 2012, 3, e00177-12. [Google Scholar] [CrossRef] [PubMed]
- Kim, H.M.; Davey, M.E. Synthesis of ppGpp impacts type IX secretion and biofilm matrix formation in Porphyromonas gingivalis. NPJ Biofilms Microbiomes 2020, 6, 5. [Google Scholar] [CrossRef]
- Kim, H.M.; Ranjit, D.K.; Walker, A.R.; Getachew, H.; Progulske-Fox, A.; Davey, M.E. A Novel Regulation of K-antigen Capsule Synthesis in Porphyromonas gingivalis Is Driven by the Response Regulator PG0720-Directed Antisense RNA. Front. Oral Health 2021, 2, 701659. [Google Scholar] [CrossRef]
- Kim, H.M.; Park, Y.H.; Yoon, C.K.; Seok, Y.J. Histidine phosphocarrier protein regulates pyruvate kinase A activity in response to glucose in Vibrio vulnificus. Mol. Microbiol. 2015, 96, 293–305. [Google Scholar] [CrossRef]
- Park, Y.H.; Lee, C.R.; Choe, M.; Seok, Y.J. HPr antagonizes the anti-sigma70 activity of Rsd in Escherichia coli. Proc. Natl. Acad. Sci. USA 2013, 110, 21142–21147. [Google Scholar] [CrossRef]
- Mulquiney, P.J.; Kuchel, P.W. Model of 2,3-bisphosphoglycerate metabolism in the human erythrocyte based on detailed enzyme kinetic equations: Equations and parameter refinement. Biochem. J. 1999, 342 Pt 3, 581–596. [Google Scholar]
- Kuchel, P.W.; Chapman, B.E.; Lovric, V.A.; Raftos, J.E.; Stewart, I.M.; Thorburn, D.R. The relationship between glucose concentration and rate of lactate production by human erythrocytes in an open perfusion system. Biochim. Biophys. Acta 1984, 805, 191–203. [Google Scholar] [CrossRef]
- Lauber, F.; Deme, J.C.; Lea, S.M.; Berks, B.C. Type 9 secretion system structures reveal a new protein transport mechanism. Nature 2018, 564, 77–82. [Google Scholar] [CrossRef]
- Neuman, H.; Debelius, J.W.; Knight, R.; Koren, O. Microbial endocrinology: The interplay between the microbiota and the endocrine system. FEMS Microbiol. Rev. 2015, 39, 509–521. [Google Scholar] [CrossRef] [Green Version]
- Kobayashi, H.; Miyazaki, Y. Distribution characteristics of salivary cortisol measurements in a healthy young male population. J. Physiol. Anthr. 2015, 34, 30. [Google Scholar] [CrossRef] [PubMed]
- Cakmak, O.; Tasdemir, Z.; Aral, C.A.; Dundar, S.; Koca, H.B. Gingival crevicular fluid and saliva stress hormone levels in patients with chronic and aggressive periodontitis. J. Clin. Periodontol. 2016, 43, 1024–1031. [Google Scholar] [CrossRef] [PubMed]
- Sam, S.; Corbridge, T.C.; Mokhlesi, B.; Comellas, A.P.; Molitch, M.E. Cortisol levels and mortality in severe sepsis. Clin. Endocrinol. 2004, 60, 29–35. [Google Scholar] [CrossRef]
- Vermilyea, D.M.; Moradali, M.F.; Kim, H.M.; Davey, M.E. PPAD Activity Promotes Outer Membrane Vesicle Biogenesis and Surface Translocation by Porphyromonas gingivalis. J. Bacteriol. 2021, 203, e00343-20. [Google Scholar] [CrossRef] [PubMed]
- Vermilyea, D.M.; Ottenberg, G.K.; Davey, M.E. Citrullination mediated by PPAD constrains biofilm formation in P. gingivalis strain 381. NPJ Biofilms Microbiomes 2019, 5, 7. [Google Scholar] [CrossRef] [PubMed]
- Shrivastava, A.; Rhodes, R.G.; Pochiraju, S.; Nakane, D.; McBride, M.J. Flavobacterium johnsoniae RemA is a mobile cell surface lectin involved in gliding. J. Bacteriol. 2012, 194, 3678–3688. [Google Scholar] [CrossRef]
- Gui, M.J. Characterization of the Porphyromonas gingivalis Protein PG1881 and Its Roles in Outer Membrane Vesicle Biogenesis and Biofilm Formation. Ph.D. Thesis, Melbourne Dental School, Melbourne, Australia, 2016. [Google Scholar]
- Xu, Q.; Shoji, M.; Shibata, S.; Naito, M.; Sato, K.; Elsliger, M.A.; Grant, J.C.; Axelrod, H.L.; Chiu, H.J.; Farr, C.L.; et al. A Distinct Type of Pilus from the Human Microbiome. Cell 2016, 165, 690–703. [Google Scholar] [CrossRef]
- Matsumoto-Mashimo, C.; Guerout, A.M.; Mazel, D. A new family of conditional replicating plasmids and their cognate Escherichia coli host strains. Res. Microbiol. 2004, 155, 455–461. [Google Scholar] [CrossRef]
- Gardner, R.G.; Russell, J.B.; Wilson, D.B.; Wang, G.R.; Shoemaker, N.B. Use of a modified Bacteroides-Prevotella shuttle vector to transfer a reconstructed beta-1,4-D-endoglucanase gene into Bacteroides uniformis and Prevotella ruminicola B(1)4. Appl. Environ. Microbiol. 1996, 62, 196–202. [Google Scholar] [CrossRef] [Green Version]

Publisher’s Note: MDPI stays neutral with regard to jurisdictional claims in published maps and institutional affiliations. |
© 2022 by the authors. Licensee MDPI, Basel, Switzerland. This article is an open access article distributed under the terms and conditions of the Creative Commons Attribution (CC BY) license (https://creativecommons.org/licenses/by/4.0/).
Share and Cite
Kim, H.-M.; Rothenberger, C.M.; Davey, M.E. Cortisol Promotes Surface Translocation of Porphyromonas gingivalis. Pathogens 2022, 11, 982. https://doi.org/10.3390/pathogens11090982
Kim H-M, Rothenberger CM, Davey ME. Cortisol Promotes Surface Translocation of Porphyromonas gingivalis. Pathogens. 2022; 11(9):982. https://doi.org/10.3390/pathogens11090982
Chicago/Turabian StyleKim, Hey-Min, Christina Magda Rothenberger, and Mary Ellen Davey. 2022. "Cortisol Promotes Surface Translocation of Porphyromonas gingivalis" Pathogens 11, no. 9: 982. https://doi.org/10.3390/pathogens11090982
APA StyleKim, H.-M., Rothenberger, C. M., & Davey, M. E. (2022). Cortisol Promotes Surface Translocation of Porphyromonas gingivalis. Pathogens, 11(9), 982. https://doi.org/10.3390/pathogens11090982

